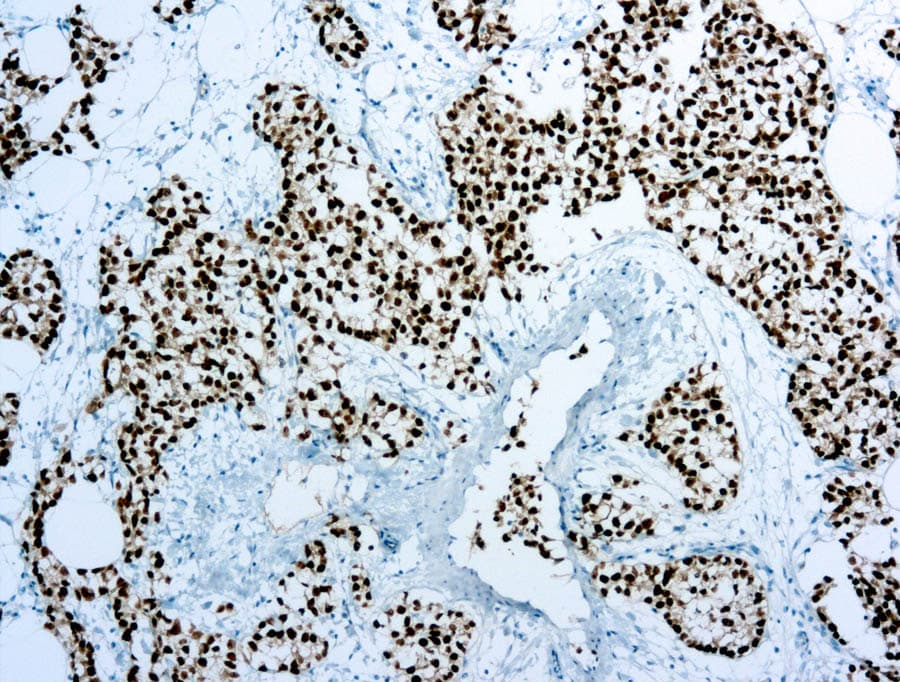

Les anticorps anti-OCT-4 (POU5F1/OTF3) sont utilisés en immunohistochimie pour la détection des marqueurs de cellules germinales pluripotentes en pathologie génito-urinaire, contribuant ainsi à l’identification précise des tumeurs germinales. Leur marquage nucléaire caractéristique, associé à des performances diagnostiques validées, en fait des composants essentiels des panels d’immunohistochimie CE-IVD dans les protocoles modernes de pathologie.
Signification biologique de l’OCT-4 (OTF3 / POU5F1)
OCT-4 est un facteur de transcription à domaine POU essentiel à la régulation de la pluripotence et au développement précoce de la lignée germinale.
- Il maintient l’auto-renouvellement des cellules souches embryonnaires et régule les voies de différenciation.
- Il est exprimé physiologiquement dans les cellules germinales primordiales et les tissus embryonnaires précoces, avec une expression somatique limitée.
- Son expression aberrante contribue à la tumorigenèse des cellules germinales en préservant un phénotype cellulaire indifférencié.
Utilité diagnostique en pathologie génito-urinaire
L’immunomarquage OCT-4 en IHC constitue un biomarqueur validé des tumeurs germinales pluripotentes.
- Une forte coloration nucléaire est observée dans le séminome, le carcinome embryonnaire et la néoplasie germinale in situ (GCNIS), avec une sensibilité et une spécificité élevées.
- Il permet de différencier les tumeurs OCT-4 positives des tumeurs du sac vitellin et des tératomes, généralement dépourvus d’expression nucléaire.
- Il est utile pour l’évaluation des maladies métastatiques et l’analyse de petits échantillons biopsiques grâce à un signal nucléaire net.
Caractéristiques clés des anticorps anti-OCT-4 CE-IVD (IHC)
Les propriétés régulièrement rapportées dans des études de validation évaluées par les pairs comprennent :
- Une immunoréactivité nucléaire prédominante, cohérente avec la biologie des facteurs de transcription.
- Une haute sensibilité analytique sur des coupes de tissus fixés au formol et inclus en paraffine utilisées en diagnostic de routine.
- Une compatibilité avec les plateformes IHC automatisées et les flux de travail CE-IVD standardisés.